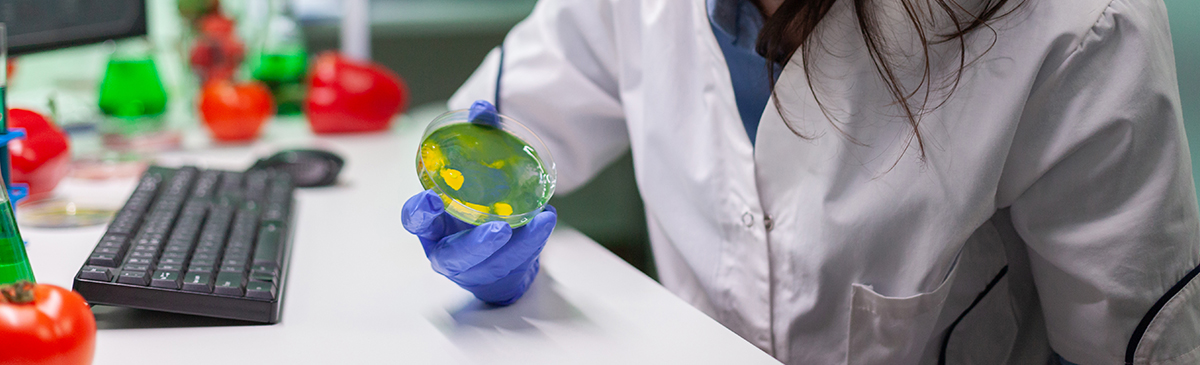

At Ceyone Life Sciences, we conduct forced degradation studies to evaluate the stability, robustness, and degradation pathways of pharmaceutical products under extreme stress conditions. These studies provide critical insights into a molecule’s intrinsic stability, enabling the design of stable formulations, improved shelf life, and comprehensive regulatory documentation.
Key Highlights
Identification of potential degradation pathways under thermal, oxidative, photolytic, and hydrolytic conditions
Data supporting impurity profiling, method validation, and stability-indicating methods
Assessment of product stability throughout its lifecycle
Ensures compliance with ICH and global regulatory requirements

